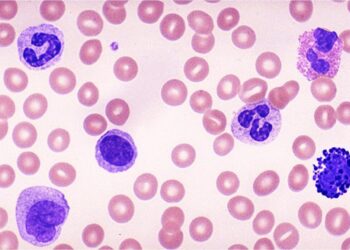

Este es el atlas del envejecimiento del músculo esquelético humano
En un mundo con sociedades que envejecen rápidamente, es necesario conocer en detalle la causa y la progresión de las enfermedades asociadas al envejecimiento. El músculo esquelético es el sistema motor clave del cuerpo humano y desempeña un papel fundamental en la regulación metabólica corporal. Investigadores de la Universidad…
23/04/2024